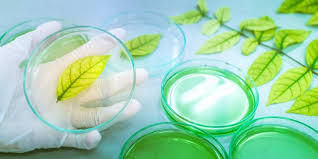

MICELÁNEO CL. CIENCIA, BIOLOGIA Y GENÉTICA.
CIENCIA, BIOLOGIA Y GENÉTICA
Por Beatriz Santos Dieguez
La
Ciencia es como un árbol,
cuyas raíces están constituidas
por todo aquello que forma parte de
nosotros y de todo lo que nos rodea, y cuyas ramas son el producto del establecimiento de determinadas hipótesis
puestas a prueba permanentemente.
Empecemos por el principio para encontrarnos con una estructura sólida que nos permita comprender lo que aquí vamos armando, o al menos lo intentamos.
La Ciencia es aquella que estudia el mundo que nos rodea, desde lo más pequeño a lo más grande.
La
ciencia se puede hacer en cualquier lugar, pero a menudo se
hace en laboratorios.
Los
laboratorios son
lugares seguros, diseñados para trabajar con productos químicos, gérmenes y
equipos científicos. En ellos puede haber
desde microscopios a agitadores para el crecimiento de bacterias
fotosintéticas, pasando por placas de
Petri para el cultivo de las células,
pipetas para medir líquidos, congeladores superfrios especiales (-80 Celsius/
-112 Fahrenheit), etc.
 |
| Placa Petri |
En ellos los
científicos trabajan con equipos
especiales, utilizando equipos de
protección.
Los
científicos son los encargados de llevar adelante la ciencia. Observan de cerca
nuestro mundo natural, haciendo conjeturas de cómo funcionan las cosas y
basándose en ellas van encontrando
formas de probarlas a través de los experimentos
científicos, los cuales se llevan a cabo
mediante la recopilación de datos
(Data).
Una vez hemos visto como
se trabaja en la ciencia, pasaremos al
siguiente concepto.
La
Biología
es una rama de la ciencia,
concretamente de las ciencias naturales.
La
palabra Biología proviene del griego y significa
“el estudio de la vida”.
Aunque tanto la ciencia como la biología se dedican a estudiar del mundo que nos rodea la biología se dedica al estudio de
los seres
vivos.
Los
seres vivos somos organismos
cuyos componentes básicos son las
células.
Las células son, por tanto los componentes básicos que forman los organismos.
La
función de los biólogos es el estudio del crecimiento y
desarrollo de los seres vivos u organismos, algunos de los cuales son tan
pequeños que se necesita microscopios para verlos, otros pueden verse a simple
vista y, algunos son tan grandes que no podemos verlos en su totalidad.
La
Biología explora todo lo
relacionado con la vida, desde el nivel molecular hasta el nivel de los
ecosistemas.
Podemos decir, por tanto,
que la Biología siendo una rama de la ciencia, se dedica a estudiar los seres vivos, sus procesos
vitales y sus interacciones con el entorno.
La
Biología busca comprender la estructura, función, evolución, desarrollo y relaciones de los seres vivos.
 |
| GENÉTICA |
La
Genética Es
la rama de la Biología que estudia
la forma en que se transmite la herencia
biológica entre las generaciones.
Su principal objetivo es
el estudio de los genes, los cuales
son unidades moleculares de información de
la herencia genética.
Dentro de los genes (concretamente en los cromosomas) se encuentra el genotipo.
El Genotipo es el conjunto de
genes que posee un individuo de cualquier especie, concretamente se
encuentra dentro del ADN o ácido desoxirribonucleico (específicamente
en los genes que forman los cromosomas).
El
ADN es la molécula que contiene la información genética esencial para el
desarrollo y funcionamiento de los seres vivos. Se encuentra, en el núcleo de cada célula.
El Genotipo se transmite de generación en generación.
También estudia el Fenotipo que son las características observables (físicas, bioquímicas y
comportamentales) de un individuo.
El
Fenotipo es el resultante de
la interacción entre su genotipo y el entorno (ambiente).
Hoy concluimos con este
somero (superficial) repaso de una rama de la ciencia llamada genética,
la cual indaga en los niveles moleculares de los seres vivos mediante el
estudio del Genotipo y del Fenotipo. Este último (Fenotipo) deja campo abierto para
indagar y estudiar otros niveles más visibles, a simple vista, de los seres
vivos.

Comentarios
Publicar un comentario